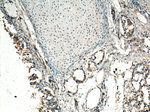
GM-CSF Antibody in Immunohistochemistry (Paraffin) (IHC (P))
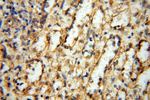
GM-CSF Antibody in Immunohistochemistry (Paraffin) (IHC (P))

Search
Proteintech
GM-CSF Polyclonal Antibody
{{$productOrderCtrl.translations['antibody.pdp.commerceCard.promotion.promotions']}}
{{$productOrderCtrl.translations['antibody.pdp.commerceCard.promotion.viewpromo']}}
{{$productOrderCtrl.translations['antibody.pdp.commerceCard.promotion.promocode']}}: {{promo.promoCode}} {{promo.promoTitle}} {{promo.promoDescription}}. {{$productOrderCtrl.translations['antibody.pdp.commerceCard.promotion.learnmore']}}
产品信息
17762-1-AP
种属反应
已发表种属
宿主/亚型
分类
类型
抗原
偶联物
形式
浓度
规格
纯化类型
保存液
内含物
保存条件
运输条件
产品详细信息
Immunogen sequence: MWLQSLLLL GTVACSISAP ARSPSPSTQP WEHVNAIQEA RRLLNLSRDT AAEMNETVEV ISEMFDLQEP TCLQTRLELY KQGLRGSLTK LKGPLTMMAS HYKQHCPPTP ETSCATQIIT FESFKENLKD FLLVIPFDCW EPVQE (1-144 aa encoded by BC108724)
靶标信息
The GM-CSF gene encodes for a cytokine that regulates the production, differentiation, and function of macrophages and granulocytes. The active form of the protein exists as a homodimer in the extracellular space. This gene is located in a cluster of related genes at the chromosome region 5q31, which has been associated with interstitial deletions in the 5q- syndrome and acute myelogenous leukemia. Other genes in the cluster include interleukins 4, 5, and 13. The gene is involved in promoting tissue inflammation. Elevated levels of cytokines, including the one produced by this gene, have been observed in SARS-CoV-2 infected patients with acute respiratory distress syndrome. Mice that lack this gene or its receptor have been shown to develop pulmonary alveolar proteinosis.
仅用于科研。不用于诊断过程。未经明确授权不得转售。
生物信息学
蛋白别名: colony stimulating factor 2 (granulocyte-macrophage); Colony-stimulating factor; CSF; GM-CSF; granulocyte macrophage colony stimulating factor; granulocyte macrophage-colony stimulating factor; Granulocyte-macrophage colony-stimulating factor; granulocyte/macrophage colony-stimulating factor; M-GM-CSF; MGC131935; MGC138897; MGC151255; MGC151257; molgramostim; Molgramostin; Sargramostim
基因别名: CSF; CSF2; GMCSF
UniProt ID: (Human) P04141
Entrez Gene ID: (Human) 1437